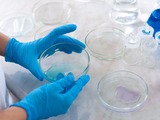

All Analytical Instruments General

Launch of three new microwave digestion systems
Added: 13 Oct 2025
Quality analysis with ICP-MS and AA/ICP-OES starts with good sample preparation and for this to be …

Gates Foundation gifts US$0.5 million to gene editing firm
Added: 11 Jun 2025
Biotech firm Gene Weaver has received more than US$515,000 from the US Gates Foundation for its gen…

LabTalk News in brief
Added: 20 May 2025
US tariffs have disappointed profit expectations for 2025/26 among Europe’s medtech manufacturers, …

US lab accreditation rules updated
Added: 7 Feb 2025
Final rule changes to the Clinical Laboratory Improvement Amendments (CLIA) feature in the 2024 edi…

Lab innovations 2024: automation and productivity in the laboratory
Added: 22 Oct 2024
With Lab innovations 2024 fast approaching, Russell Lotinga of show exhibitor Festo, explains how a…

Lab Innovations opens for registration and bumper 2024
Added: 17 Aug 2024
Visitor registration has opened for Lab Innovations 2024, which takes place at Birmingham NEC from …

Bruntwood wins go-ahead for massive expansion to Melbourn Science Park
Added: 18 Mar 2024
Bruntwood SciTech has won planning approval for nearly 0.4million sq ft of specialist lab and offic…

Lab disaster destroys Karolinska samples worth millions
Added: 11 Feb 2024
Sweden’s prestigious Karolinska Institutet has launched an investigation after a malfunctioning fre…

The latest advances in nanoparticle tracking analysis from Meritics
Added: 25 Jul 2023
Meritics is a UK distributor for the ViewSizer 3000, designed to visualise and determine the size d…

Hurry before deadline falls for 2023 Lab Awards’ 13 categories!
Added: 25 Jul 2023
You have just three days to make the deadline for nominations for the expanded, 13 category 2023 La…

LAB ROUNDUP 22 May – data conversion, DNA synthesis, BBB, preeclampsia testing and more
Added: 21 May 2023
Biotech industry R&D Cloud Benchling called for standardised instrument data conversion in the scie…

Measure, analyse and control particle concentration with Meritics
Added: 10 May 2023
Particle concentration is one of the fields in which Meritics supplies systems designed to measure,…

Medicines Discovery Catapult celebrates five years of achievement
Added: 8 May 2023
National innovation centre for drug discovery the Medicines Discovery Catapult is marking the fifth…

Particle Count Analysis from Meritics
Added: 31 Mar 2023
Meritics supplies systems for all stages in research, development, and manufacturing – enabling mea…

LAB ROUNDUP 27 March: Virology, automation, anniversaries, lab builds, awards, product innovation
Added: 26 Mar 2023
Edinburgh-based engineering biology pioneer Ingenza, celebrates its 20thanniversary with an event o…

Lab roundup: ValiRx., Fujitsu. Cherwell. OBN, Atmonia, Uniogen, EU
Added: 10 Mar 2023
ViroCell Biologics has appointed former Oxford Biomedica (OXB) CEO John A. Dawson as Chairman of it…

Lab roundup: Automata-Crick partnership, EPSRC £2mill, Tetra-Pak milestone
Added: 15 Feb 2023
Genomics ramps up the automation, the chance to host a national research facility, a flow cytometry…

London Institute of Medical Sciences’ cutting-edge HQ complete
Added: 24 Jan 2023
The Medical Research Council’s new home for its London Institute of Medical Sciences has reached co…
Lab’s failures led to nearly 40,000 false negative COVID tests, says UKHSA
Added: 29 Nov 2022
A clinic set up just months after the initial outbreak of Covid-19 cases in the UK issued thousands…

Cambridge spin-out secures £2.4 million for tumour treatments
Added: 21 Jun 2022
University of Cambridge spin-out Spirea Limited has secured £2.4 million in funding from British an…

